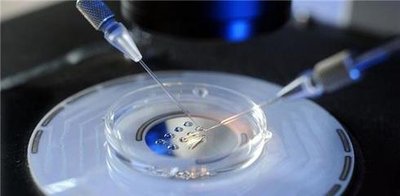

一代试管婴儿比二代好吗?妊娠率有差异吗?
在辅助生殖技术飞速发展的今天,许多不孕不育夫妇将“试管婴儿”视为圆梦生育的希望。然而,面对“一代”“二代”“三代”试管婴儿技术,不少人感到困惑:这些技术究竟有何区别?是不是代数越高技术越先进?尤其是一代试管婴儿(IVF)和二代试管婴儿(ICSI)之间,哪个成功率更高?妊娠率是否存在显著差异?本文将为您深入解析。
什么是第一代和第二代试管婴儿?
首先需要明确的是,“代”的划分并非代表技术的先进程度或成功率的高低,而是指受精方式的不同。
第一代试管婴儿(常规体外受精,IVF)
这项技术主要适用于女性因素导致的不孕,如输卵管堵塞、排卵障碍、子宫内膜异位症等。其核心原理是将取出的卵子和经过处理的精子放在培养皿中,让它们自然结合、完成受精过程,模拟体内受孕的环境。简单来说,就是“让精子和卵子自由恋爱”。
第二代试管婴儿(卵胞浆内单精子注射,ICSI)
这项技术主要针对男性不育问题,如严重的少精、弱精、畸精症,或既往IVF周期中受精失败的情况。ICSI技术由胚胎学家在显微镜下用一根极细的玻璃针,将单个精子直接注射到卵子内部,强制完成受精。这相当于“包办婚姻”,确保受精发生。
一代和二代,哪个更好?
“更好”这一说法并不准确。选择一代还是二代,关键在于适应症的匹配,而非技术本身的优劣。
如果是女性因素不孕,且男方精液质量正常,通常首选第一代试管婴儿。这种方式更接近自然受孕过程,对卵子的损伤相对较小。
如果是严重的男性因素不育,如精子数量极少或活力极差,自然受精几乎不可能成功,此时第二代试管婴儿是更合适的选择。
因此,不能简单地说“一代比二代好”或“二代比一代好”。正确的选择应由生殖医生根据夫妻双方的具体检查结果来决定。

妊娠率有差异吗?
这是许多患者最关心的问题。从临床妊娠率(即通过B超看到孕囊)和活产率
的角度来看,一代和二代试管婴儿在适应症匹配的情况下,整体成功率并无显著差异。
多项研究数据显示:
对于非男性因素不孕的患者,采用IVF(一代)的受精率和妊娠率通常较为理想。
对于男性因素不孕患者,ICSI(二代)显著提高了受精率,从而避免了因受精失败导致的周期取消,最终的妊娠率与IVF相当甚至更高。
值得注意的是,ICSI虽然解决了受精难题,但并不能改善精子本身的遗传质量。一些研究提示,ICSI可能略微增加某些罕见遗传疾病或出生缺陷的风险,因此在非必要情况下不建议盲目使用。
如何选择适合自己的技术?
全面检查:夫妻双方需进行系统的不孕不育检查,明确病因。
医生评估:生殖专家会根据精液分析、卵巢功能、输卵管状况等综合判断,推荐最适合的技术。
个体化方案:现第三方辅助生育殖中心常采用“混合授精”策略,即在同一周期中部分卵子采用IVF,部分采用ICSI,以提高整体受精机会。
结语
一代试管婴儿和二代试管婴儿各有其适用场景,技术本身并无绝对的“好坏”之分。妊娠率的高低更多取决于患者年龄、卵巢储备、胚胎质量、子宫环境等综合因素,而非单纯的技术代数。对于不孕夫妇而言,最重要的是在专业医生的指导下,选择最适合自身情况的治疗方案,理性看待技术差异,才能最大程度提高成功怀孕的几率。
科学助孕,始于正确的认知。选择适合的,才是最好的。想了解更适合自己的试管方案?欢迎联系泰嘉运,一对一为您定制专属计划。
本文链接:https://www.taijiayun.cn/a_961.html

朱姐